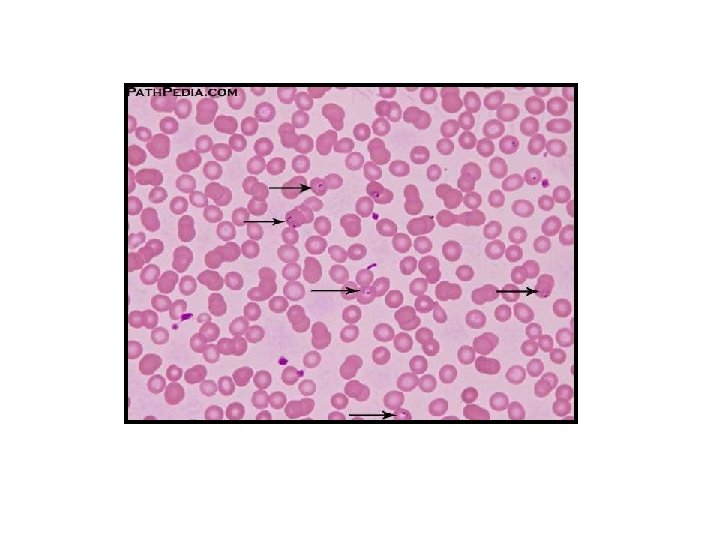
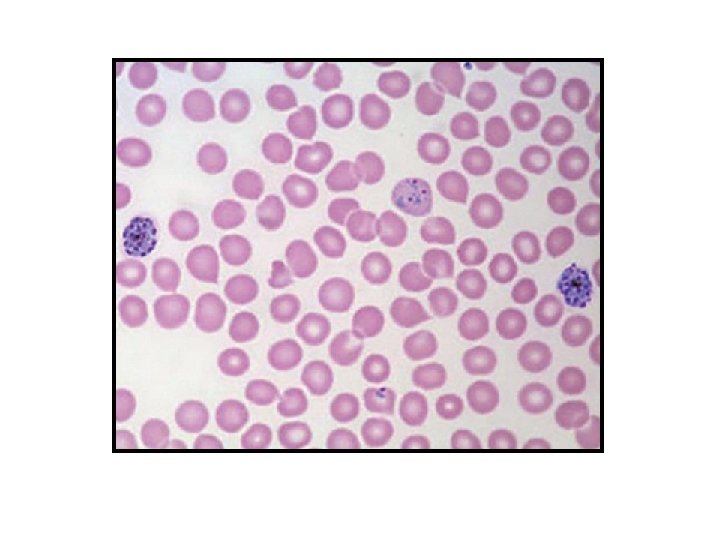

MALARIA Intermittent fever with chills and shivering Causative


























- Slides: 26

MALARIA • Intermittent fever with chills and shivering • Causative agent = plasmodium species • Protozoan parasite • Member of apicomplexa • 4 species infecting humans • Transmitted by female anopheles mosquitoes

• Consists of 4 species: 1. P. vivax 2. P. falciparum 3. P. malariae 4. P. ovale

Transmission & Life Cycle Definitive host Female Anopheles mosquito Intermediate host Man Infective form Sporozoites Portal of entry Skin Site of localization First in liver cells & then in RBCs




Phases of Development in Man Two phases of development: 1. Inside the liver (tissue phase) – – Pre- erythrocytic schizogony – no clinical symptoms, no pathological damage Exo- erythrocytic schizogony – cause of relapse 2. Inside the RBCs (erythrocytic phase) – – Erythrocytic schizogony – cause of malarial paroxsyms Gametogony – infects mosquito

Pathogenicity • Infection causes intermittent fever – Malaria • Each of the 4 species causes a characteristic fever: P. vivax P. falciparum P. ovale P. malariae Tertian (BT) Tertian (MT) Tertian Quartan malaria

Clinical Features • IP: 7 to 30 days • Series of febrile paroxysms – fever is caused by the release of merozoites & toxins from ruptured erythrocytic schizont which in turn causes the release of cytokines. Tertian malaria - every 48 hrs Quartan malaria – every 72 hrs Each paroxysm has 3 stages : 1. cold stage 2. hot stage 3. Sweating stage

• Fever • Chills • Sweats • Headaches • Nausea and vomiting • Body aches • General malaise • Recrudescences and relapses can occur over months or years • Can develop severe complications (especially P. Falciparum)

• Severe Malaria • Cerebral malaria, with abnormal behavior, impairment of consciousness, seizures, coma, or other neurologic abnormalities • Severe anemia due to hemolysis (destruction of the red blood cells) • Hemoglobinuria (hemoglobin in the urine) due to hemolysis • Acute respiratory distress syndrome (ARDS), an inflammatory reaction in the lungs that inhibits oxygen exchange, which may occur even after the parasite counts have decreased in response to treatment • Abnormalities in blood coagulation • Low blood pressure caused by cardiovascular collapse

• Acute kidney failure • Hyperparasitemia, where more than 5% of the red blood cells are infected by malaria parasites • Metabolic acidosis (excessive acidity in the blood and tissue fluids), often in association with hypoglycemia • Hypoglycemia (low blood glucose). Hypoglycemia may also occur in pregnant women with uncomplicated malaria, or after treatment with quinine.

Malaria Paroxysm • paroxysms associated with synchrony of merozoite release • between paroxysms temperature is normal and patient feels well • falciparum may not exhibit classic paroxysms (continuous fever) tertian malaria quartan malaria

Malaria Relapses • In P. vivax and P. ovale infections • Patients having recovered from the first episode of illness may suffer several additional attacks ("relapses") after months or even years without symptoms. • Relapses occur because P. vivax and P. ovale have dormant liver stage parasites ("hypnozoites") that may reactivate.

1. Anaemia 2. Blackwater fever 3. Pernicious malaria/algid malaria 4. Tropical Splenomegaly syndrome

Recurrence of Malaria • Two types of recurrences known in malaria: 1. Recrudescence – – – seen in P. falciparum & P. malariae due to persistence of blood infection (some erythrocytic forms evade host immunity) even after clinical illness has subsided. The numbers may increase later, leading to reappearance of clinical symptoms Occur usually within 4 to 8 months.

2. Relapse – Occurs due to a special form of parasites – hypnozoites. – Hypnozoites are the sporozoites that remain dormant after infecting liver – Activated from time to initiate pre erythrocytic schizogony - Exoerythrocytic schizogony, usually 2 to 5 years.

Laboratory Diagnosis 1. Microscopy – detecting & identifying malarial parasites in peripheral blood films. 2. Concentration: To concentrate parasites in venous blood by centrifugation when they can not be found in blood films 1. New methods: Using a rapid malaria Ag or enzyme detection test

1. Thick films : - more suitable for detection of malarial parasite when they are few in number - 30 to 40 times more sensitive than thin films 2. Thin films : - To confirm the Plasmodium species - Assists in the identification of mixed infections

Quantitative Buffy Coat (QBC) (Beckton Dickinson)


Malaria prevention 1. Personal prophylaxis is by avoiding mosquito bites : a. Mosquito nets. (Permethrin) b. Repellents (Diethyltolumide) c. Chemoprophylaxis 2. Control: a. Prevention of breeding sites b. Fog spraying.

Treatment: 1. Chloroquine 2. Primaquine 3. Sulphadoxine and Mefloquine 4. Quinine